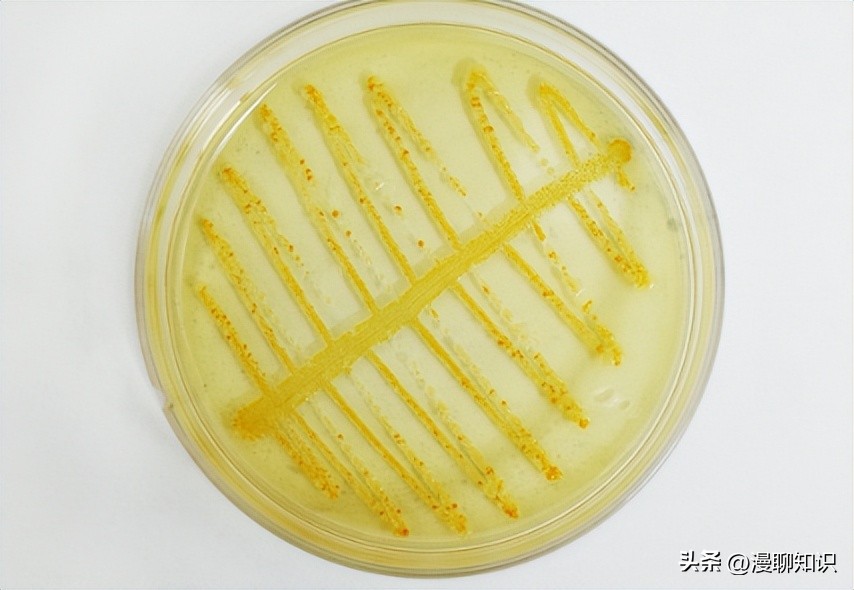
大肠杆菌的结构名称,大肠杆菌菌株基因型
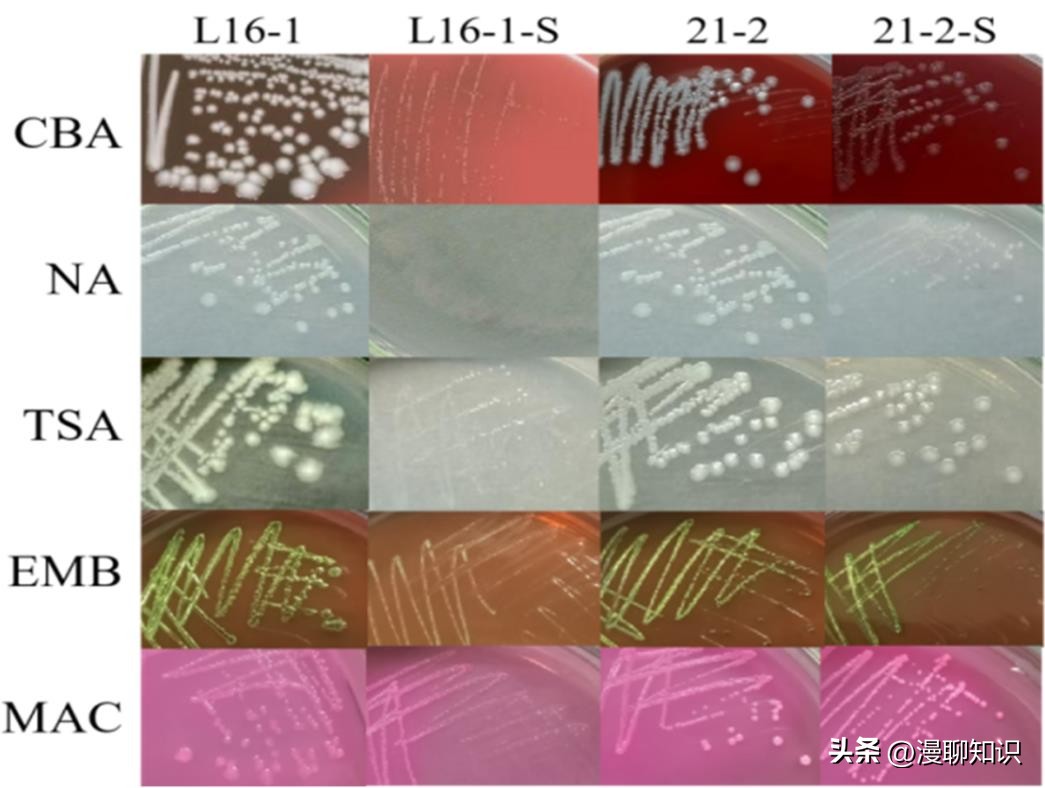
大肠杆菌的结构名称,大肠杆菌菌株基因型

在阅读此文前,诚邀您请点点右上方的“关注”,既方便您进行讨论与分享,还能及时阅读最新内容,感谢您的支持。
大肠杆菌(Escherichia coli, EC)是一种既在自然界如水、空气和土壤等中广泛存在,又可以寄生在人和哺乳动物肠道、泌尿生殖道或乳房等组织中的人畜共患菌。
在正常情况下,寄居于肠道的大肠杆菌是肠道正常菌群的组成成员,但当肠道内正常菌群中的大肠杆菌(通常为非致病性大肠杆菌)寄生部位发生改变或有致病性大肠杆菌(肠外致病性大肠杆菌或肠道致病性大肠杆菌等)侵入时,可以引起多种人畜疾病,如腹泻、尿路感染、脑膜炎、腹膜炎、败血症、肺炎和奶牛乳腺炎等。
同时,大肠杆菌也是医院临床和细菌性食物中毒的主要病原菌之一。
因此大肠杆菌的感染(或污染)给公共卫生安全与食品生产安全带来严重威胁。

随着研究的深入,多种病原菌的特殊形式被相继报道,如生物被膜(Biofilm, BF)、持留性细胞(persister cell, PC)和小菌落变异体(Small Colony Variants, SCVs)等。
其中细菌SCVs因其耐药性和持留能力增强而被认为有更大的公共卫生安全和食品生产安全隐患,从而被越来越多的科研工作者关注。
SCVs是细菌在抗生素或其他恶劣条件下诱导形成的一种特殊存在形式,通常表现为电子传递受阻或缺失,ATP合成不足,代谢缓慢,是正常菌落大小的1/10,可对多种抗生素表现出耐药性。
不仅如此,SCVs可以使细菌隐藏在宿主细胞内而不引起强烈的宿主反应,实现免疫逃避,造成持续性复发感染,给临床治疗带来很大困难。
这种特殊的细菌生存形式可能并不与某一种药物的耐受性直接相关,但其特殊的生理生化代谢方式却可以使病原菌对多种药物耐受。
随着研究的深入,研究者发现了这些特殊的细菌存在形式,不但形成原因复杂,能不断发生变化和转化,在细菌耐药和持续残留等过程中发挥着重要作用,并且广泛存在于细菌中。

目前关于细菌SCVs的感染、宿主体内持留和耐药机制的研究多来自金黄色葡萄球菌,但已有相关报道称数十种细菌均可形成SCVs。
国内外关于EC-SCVs的报道较少,大部分来自人医临床病例或体外诱导,通常会造成疾病的反复发作与慢性感染。
关于动物源大肠杆菌的报道更是少之又少,因此本研究选用氨基糖苷类抗生素诱导动物源大肠杆菌形成SCVs,并比较分析野生株和SCVs在生理生化特性、药物敏感性、运动性、溶血活性和生物被膜形成能力等方面的差异,探究大肠杆菌及其SCVs的生物学特性差异,以期为国内动物源EC-SCVs的相关研究提供基础实验数据。

材料与方法
材料
动物源大肠杆菌分别来源于*疆新**的奶牛(6株,巴音郭楞蒙古自治州)、绵羊(10株,阿克苏地区)和马(4株,伊犁地区),对照菌株大肠杆菌ATCC 25922(phoA阳性菌株)和表皮葡萄球菌ATCC 35984(强生物被膜形成能力)保存于*疆新**生产建设兵团塔里木畜牧科技重点实验室;健康绵羊血由*疆新**生产建设兵团塔里木动物疫病诊断与防控工程实验室提供
PCR引物、Tris-HCl、SDS、EDTA、Taq PCR Master Mix(2×)试剂盒,生工生物工程(上海)股份有限公司;药敏片,温州市泰康生物科技有限公司;胰蛋白胨大豆琼脂/液体培养基(Tryptic soy agar, TSA; Tryptic soy broth, TSB)、水解酪蛋白胨琼脂/液体培养基(Mueller-Hinton agar, MHA; Mueller-Hinton broth, MHB)、麦康凯琼脂培养基(Mac conkey, MAC)、伊红美蓝琼脂培养基(Eosin-methylene blue medium, EMB)、哥伦比亚血琼脂(Columbia blood agar, CBA)和营养肉汤/琼脂(Nutrient broth, NB; Nutrient agar, NA),青岛海博生物科技有限公司;甲萘醌(Menadione, VK3)、氯化血红素(Heme, H)和胸腺嘧啶脱氧核苷(Thymidine, TD),北京索莱宝科技有限公司;EasyPureBacteria Genomic DNA Kit,北京全式金生物科技有限公司;RIPA裂解液(无*制剂抑**),上海碧云天生物科技有限公司。
PCR仪、凝胶成像系统、电泳仪,Bio-Rad公司;高通量实时微生物生长分析仪,天津杰灵仪器制造有限公司。
运动力培养基(g/L):胰蛋白胨10.0,氯化钠5.0,阿拉伯糖1.5,琼脂3.0。

大肠杆菌SCVs的诱导与筛选
将大肠杆菌从甘油管中划线接种在TSA平板上37 ℃培养过夜,然后将复苏后的菌株转接在5 mL TSB培养基中37 ℃、180 r/min培养4-6 h后,将菌悬液用无菌生理盐水稀释至1×106 CFU/mL。
取200 μL稀释后的菌悬液均匀涂布于TSA平皿上,将含有30 μɡ/片的卡那霉素滤纸片和含有5 μɡ/片的庆大霉素滤纸片贴于TSA表面,37 ℃培养18-24 h,得到F1代。
蘸取F1代抑菌圈边缘单菌落或菌苔接种于TSB培养基中,37 ℃、180 r/min培养24-56 h,然后划线分离纯化,观察是否有生长缓慢、呈针尖状的小菌落出现。
若无特征菌落出现,则将F1代细菌悬液用无菌生理盐水稀释至1×106 CFU/mL,取200 μL稀释后的菌悬液涂布于TSA上,增加抗生素浓度(随着传代次数依次增加抗生素含量)再重复上述步骤(卡那霉素含量:F2代:60 μɡ/片;F3代:90 μɡ/片;F4代:120 μɡ/片。
庆大霉素含量:F2代:10 μɡ/片;F3代:20 μɡ/片;F4代:40 μɡ/片),直到有特征菌落出现或至抗生素含量最高。
将标记为第1代的大肠杆菌SCVs菌株在血平板上进行传代培养,传代10次及以上以验证其稳定性。
大肠杆菌及其SCVs的特异性基因检测与MLVA分析
按照EasyPure Bacteria Genomic DNA Kit操作流程和要求提取大肠杆菌及其SCVs的基因组DNA。
以大肠杆菌标准菌株ATCC 25922为阳性对照,使用引物phoA-F(5ʹ-GTGACAAAAGCCCGGACACCATAAATGCCT-3ʹ)和phoA-R(5ʹ-TACACTGTCATTACGTTGCGGATTTGGCGT-3ʹ)PCR扩增大肠杆菌及其SCVs特异性phoA基因,预期扩增产物大小为720 bp。
PCR反应条件:95℃ 5 min;95℃ 50 s,55℃ 50 s,72℃ 1 min,共30个循环;72℃ 7 min。
PCR反应体系按照Taq PCR Master Mix(2×)试剂盒说明书配制。

多位点可变数目串联重复序列分析(Multiple Locus Variable-number tandem repeat Analysis, MLVA)是一种基于PCR技术的分型方法,通过区分基因组上多个具有多态性串联重复序列位点(Variable Number of Tandem Repeats,VNTR)的重复数来区分菌株。
参考文献中的实验方法对大肠杆菌及其SCV进行MLVA分析,反应条件:94℃ 5 min;94℃ 30 s,55℃ 30 s,72℃ 90 s,30 个循环;72℃10 min;4℃保存。

大肠杆菌SCVs的营养缺陷型测试
将大肠杆菌SCVs转接至TSB培养基中37 ℃、180 r/min恒温培养过夜,然后将菌悬液涂布于TSA培养基上,然后分别滴加10 μL 5 mg/mL的甲萘醌、氯化血红素和胸腺嘧啶脱氧核苷于TSA培养基上,在有氧条件下37℃恒温培养24-48 h。
同时将大肠杆菌SCVs划线接种于血平板上,在5% CO2的条件下37℃恒温静置培养24-48 h,观察是否有回复现象。
大肠杆菌及其SCVs培养特性和生化试验
将大肠杆菌及其SCVs划线接种于麦康凯、伊红美蓝、胰蛋白胨大豆琼脂培养基和营养琼脂(NA)上,置于37℃恒温培养24 h观察其在不同培养基上的生长情况。
分别以大肠杆菌ATCC 25922和无菌生理盐水为阳性和空白对照,按照生产厂家的操作说明,使用微量生化鉴定管对大肠杆菌及其SCVs进行糖类分解试验(葡萄糖、乳糖、山梨醇、甘露醇)、触酶试验、硝酸盐还原试验和醋酸盐利用试验。

大肠杆菌及其SCVs生长曲线测定和胞内ATP含量测定
使用高通量实时微生物生长分析仪对大肠杆菌及其SCVs进行生长曲线的测定,先将待测菌株接种于TSB培养基中37 ℃、180 r/min恒温培养过夜,然后1:200接种于TSB培养基,放入仪器中检测,总体积为1 mL,37 ℃、800 r/min恒温培养24 h。
参照ATP检测试剂盒生产厂家的操作要求与标准,将大肠杆菌与SCVs培养液于8 000 r/min离心2 min后去除上清液,然后使用RIPA(无*制剂抑**)细胞裂解液处理后12000 r/min离心2 min,取上清按照试剂盒操作要求进行胞内ATP含量测定。

大肠杆菌及其SCVs运动力比较
使用新鲜的运动力培养基对大肠杆菌及其SCVs是否有运动力进行半定量检测。
将配制好的新鲜运动力检测平板干燥15 min,将培养至对数期(野生株、25-1-S、1-12-S在TSB中37 ℃、180 r/min恒温培养5 h;21-2-S、L16-1-S、L16-1-S-CN在TSB中37 ℃、180 r/min恒温培养8 h)的菌悬液稀释至1×107 CFU/mL,取2 μL稀释后的菌悬液滴加在运动力检测平板上,37 ℃恒温培养24 h后测量其运动直径。
大肠杆菌及其SCVs溶血活性的测定
以含有3%绵羊红细胞的dd H2O 混合液为阳性对照,含3%绵羊红细胞的PBS混合液为阴性对照。
将菌株接种于TSB培养基中,37 ℃、180 r/min恒温培养过夜复苏后,转接在5 mL TSB培养基,37 ℃、180 r/min恒温培养过夜后,12 000 r/min离心2 min收集细菌培养上清液,取100 μL加入900 μL含3%绵羊血细胞的PBS混合,37℃孵育30 min后8000 r/min离心2 min,在540 nm处测定上清液溶血程度。

大肠杆菌及其SCVs生物被膜形成能力检测
以表皮葡萄球菌ATCC 35984为阳性对照,以等体积的TSB培养基为空白对照,用96孔板法半定量测定大肠杆菌及其SCVs形成生物被膜的能力。
操作方法为:将菌株接种于TSB培养基中,37 ℃、180 r/min恒温培养过夜复苏后,转接到TSB培养基中培养至菌液呈云雾状,然后用新鲜的TSB培养基以1:100稀释,吸取200 μL稀释液至96孔板中。
37℃静置培养48 h后,用无菌水洗去未黏附细菌。
56℃烘干固定后,用0.5%结晶紫染色5 min,冲洗、晾干后使用*酮丙**:乙醇(体积比为2:8)进行溶解,测定OD570。

大肠杆菌及其SCVs的药物敏感性检测
根据美国临床和实验室标准协会指南(Clinical and Laboratory Standards Institute,CLSI, 2017)标准操作和判断标准,以大肠杆菌ATCC 25922为质控菌株,采用纸片扩散法对大肠杆菌及其SCVs进行八大类17种药物敏感性检测。
包括β-内酰胺类的亚胺培南(Imipenem, IPM)、青霉素(Penicillin, P)、氨苄西林(Ampicillin, AMP)和头孢噻吩(Cefalotin, KF),四环素类的替加环素(Tigecycline, TGC)和四环素(Tetracycline, TE),喹诺酮类的诺氟沙星(Norfloxacin, NOR)和恩诺沙星(Enrofloxacin, ENR),氯霉素类的氟苯尼考(Florfenicol, FFC)和氯霉素(Chloramphenicol, C),磺胺类的复方新诺明(sulfamethoxazole-trimethoprim, SXT),氨基糖苷类的卡那霉素(Kanamycin, K)、庆大霉素(Gentamicin, CN)、链霉素(Streptomycin, S)和阿米卡星(Amikacin, AK),利福霉素类的利福平(Rifampicin, RD),多肽类的多粘菌素B(Polymyxin B, PB)。

数据分析
使用GraphPad Prism 7软件分析数据(t检验)并作图,P<0.05数据具有显著性差异(*:P<0.05;**:P<0.01;***:P<0.001;****:P<0.0001;ns:差异不显著)。
结果与分析
大肠杆菌SCVs的筛选
使用氨基糖苷类抗生素对20株动物源大肠杆菌进行诱导,挑取抑菌圈边缘出现无色透明状的单菌落/菌苔,然后转接于TSB中。
其中4株大肠杆菌(编号为25-1、1-12、21-2和L-16-1)的诱导株生长缓慢,经10次传代确定其稳定性,标记为大肠杆菌SCVs菌株(编号为25-1-S、1-12-S、21-2-S、L16-1-S和L16-1-S-CN)。
表1 菌株来源与诱导结果
|
野生菌株 Wild strains |
来源 Source |
系统发育群 Phylogenetic groups |
SCVs编号 SCVs isolates |
诱导药物 Antimicrobial |
营养依赖型 Nutrition-dependent |
|
L16-1 |
绵羊 Sheep |
A |
L16-1-S-CN |
庆大霉素Gentamicin (5 μɡ) |
血红素 Heme |
|
L16-1-S |
卡那霉素Kanamycin (60 μɡ) |
血红素 Heme |
|||
|
25-1 |
马 Horse |
B1 |
25-1-S |
卡那霉素Kanamycin (30 μɡ) |
未知 Unknown |
|
1-12 |
奶牛 Cow |
B1 |
1-12-S |
卡那霉素Kanamycin (60 μɡ) |
未知 Unknown |
|
21-2 |
马 Horse |
B1 |
21-2-S |
卡那霉素Kanamycin (120 μɡ) |
未知 Unknown |
大肠杆菌及其SCVs的特异性基因检测与MLVA分析结果
所有大肠杆菌及其SCVs均扩增出大肠杆菌的特异性基因phoA,并且MLVA分析表明大肠SCVs和野生株并无差异。

大肠杆菌及其SCVs特异性基因phoA电泳图 M:DL2000 DNA marker;1:阳性对照,大肠杆菌ATCC 25922;2-4:待检菌株,依次为L16-1、L16-1-S和L16-1-CN;5:空白对照

大肠杆菌(L16-1)及其SCVs(L16-1-S和L16-1-S-CN)的MLVA分析 M:DL2000 DNA marker;1-3:rhaD,依次为L16-1、L16-1-S和L16-1-S-CN(下同);4-6:rsxC;7-9:tRNA-Arg;10-12:ftsK;13-15:tolA;16-18:hemY;19-21:ytfL;22:空白对照
大肠杆菌SCVs的营养缺陷型测试结果
EC-SCVs菌株L16-1-S和L16-1-S-CN在滴加血红素的周围出现回复现象,在甲萘醌、胸腺嘧啶脱氧核苷和CO2培养下未出现回复现象。
21-2-S、1-12-S和25-1-S在血红素、甲萘醌、胸腺嘧啶脱氧核苷或CO2培养条件下均未出现回复现象,不属于这4种常见的营养缺陷型SCVs。

大肠杆菌SCVs(L16-1-S)的营养缺陷型检测结果图 A为在滴加补充血红素(H)的周围出现回复菌落,而在甲萘醌(VK3)和胸腺嘧啶脱氧核苷(TD)的周围并未出现回复菌落。
B为在5% CO2条件下培养大肠SCVs菌株,在血平板上未出现回复菌落。
大肠杆菌及其SCVs培养特性和生化试验结果
对野生株及其SCVs进行乳糖、山梨醇、甘露醇和葡萄糖发酵试验,以及触酶试验、硝酸盐还原试验和醋酸盐利用试验。
野生株及其SCVs均发酵利用葡萄糖和乳糖,但野生株均利用醋酸盐,而诱导株均不利用醋酸盐。
表2 大肠杆菌及其SCVs生化实验
|
菌株 isolates |
乳糖 Lactose |
山梨醇 Sorbitol |
甘露醇 Mannitol |
葡萄糖 Glucose |
触酶 Catalase test |
硝酸盐 Nitrate |
醋酸盐 Acetate |
|
L16-1 |
+ |
+ |
+ |
+ |
+ |
+ |
+ |
|
L16-1-S |
+ |
- |
- |
+ |
- |
- |
- |
|
L16-1-S-CN |
+ |
- |
- |
+ |
- |
- |
- |
|
25-1 |
+ |
+ |
+ |
+ |
+ |
+ |
+ |
|
25-1-S |
+ |
+ |
+ |
+ |
+ |
+ |
- |
|
1-12 |
+ |
+ |
+ |
+ |
+ |
+ |
+ |
|
1-12-S |
+ |
+ |
+ |
+ |
+ |
+ |
- |
|
21-2 |
+ |
+ |
+ |
+ |
+ |
+ |
+ |
|
21-2-S |
+ |
+ |
+ |
+ |
+ |
+ |
- |
注:“+”:阳性;“-”:阴性Note: "+" : positive; "-" : negative.
与野生株相比,L16-1-S和L16-1-S-CN在血平板和TSA培养基上生长缓慢,呈无色透明的针尖状小菌落,在麦康凯培养基上呈玫红色的小菌落,在伊红美蓝培养基上呈带金属光泽的小菌落,而在NA培养基上不生长。
相较于野生株,21-2-S、25-1-S、1-12-S在血平板和TSA培养基上的菌落更扁平、更透明,并未形成小菌落,在麦康凯上呈玫红色的大菌落,在伊红美蓝培养基呈带金属光泽的菌落,与野生株差异不明显,而在NA培养基上生长缓慢,呈透明状、圆形、扁平小菌落,与野生株相比差异明显。
大肠杆菌及其SCVs不同培养特性
大肠杆菌及其SCVs生长曲线测定和胞内ATP含量测定结果
对野生株及其SCVs的生长曲线测定结果表明,相较于野生株,诱导株进入对数生长期的时间延后,对数生长期大幅缩短,提前进入平衡期,并且进入平衡期的细菌总OD830值也大幅下降。
胞内ATP的含量检测结果也表明,EC-SCVs胞内ATP含量均低于野生株。

大肠杆菌及其SCVs生长曲线测定(A)和胞内ATP含量差异(B)
大肠杆菌及其SCVs运动力、溶血活性和生物被膜形成能力检测结果
与野生株相比,只有血红素依赖型EC-SCVs的溶血活性增强,而3株未知类型的EC-SCVs溶血活性并未增强,但EC-SCVs的运动性均降低。
另外,除25-1-S外,其他EC-SCVs的生物被膜形成能力均增强。

大肠杆菌及其SCVs溶血活性(A)、运动性(B)和生物被膜(C)差异 *:P<0.05;**:P<0.01;***:P<0.001;****:P<0.0001;ns:差异不显著
大肠杆菌及其SCVs的药物敏感性检测结果
药敏试验结果表明,EC-SCVs对氨基糖苷类抗生素的耐受性增强,尤其是血红素依赖型EC-SCVs对测试的4种氨基糖苷类抗生素的耐受性均增强。
另外,血红素依赖型EC-SCVs对复方新诺明的耐受性也增强。
表3 大肠杆菌及其SCVs的药敏试验结果
|
分类 Class |
抗菌药物 Antimicrobial |
试验结果 / Results |
||||||||
|
L16-1 |
L16-1-S |
L16-1-S-CN |
21-2 |
21-2-S |
1-12 |
1-12-S |
25-1 |
25-1-S |
||
|
β-内酰胺类 β-Lactams |
IPM |
S |
S |
S |
S |
S |
S |
S |
S |
S |
|
p |
R |
R |
R |
S |
S |
R |
R |
R |
R |
|
|
AMP |
S |
S |
S |
I |
I |
R |
R |
I |
I |
|
|
KF |
I |
S |
S |
I |
I |
R |
R |
I |
I |
|
|
四环素类 Tetracyclines |
TGC |
S |
S |
S |
S |
S |
I |
I |
S |
S |
|
TE |
I |
S |
S |
S |
S |
R |
R |
S |
S |
|
|
喹诺酮类 Fluoroquinolones |
NOR |
S |
S |
S |
S |
S |
S |
S |
S |
S |
|
ENR |
S |
S |
S |
S |
S |
R |
R |
S |
S |
|
|
氯霉素类 Phenicols |
FFC |
S |
S |
S |
S |
S |
R |
R |
S |
I |
|
C |
S |
S |
S |
S |
S |
R |
R |
I |
S |
|
|
磺胺类 Sulphonamides |
SXT |
S |
R |
R |
S |
S |
R |
R |
S |
S |
|
氨基糖苷类 Aminoglycosides |
K |
S |
R |
R |
S |
R |
I |
I |
S |
S |
|
CN |
S |
R |
I |
S |
R |
S |
S |
S |
S |
|
|
S |
I |
R |
R |
R |
R |
R |
R |
I |
I |
|
|
AK |
S |
R |
R |
S |
R |
I |
I |
S |
S |
|
|
利福霉素 Rifamycins |
RD |
R |
R |
R |
R |
R |
R |
R |
R |
R |
|
多肽类 Polymyxins |
PB |
R |
I |
I |
I |
S |
R |
R |
R |
R |
注:S:敏感;I:中介;R:耐药
目前尚无关于细菌SCVs的大规模流行报道,因其生长缓慢易被生长迅速的野生菌株覆盖,并且与其他细菌混合感染时易被当作杂菌而忽略。
因此,在实验室通过药物诱导获得SCVs菌株成为了解其生物学特性与差异的一种重要方式。
目前关于SCVs的诱导方法只有零星报道,而且通常是在液体培养基中添加特定浓度的抗生素进行诱导培养,然后划线分离纯化,通过观察菌落特征选择符合要求的菌落再进行传代培养与鉴定。
此方法的不足在于:(1)液体培养基中的抗生素浓度均一,为恒定值,而为了选择最适的诱导浓度需要同时设置多个药物浓度进行诱导,工作量较大;(2)SCVs在划线分离纯化过程中易被生长迅速的野生型菌株覆盖,不易得到SCVs。
本课题组在此基础上提出一种新的诱导细菌形成SCVs的制备方法,将其改良为“在固体培养基表面贴上含有抗生素的滤纸片,使其形成以滤纸片为中心的连续药物梯度浓度”,可简化细菌SCVs诱导和纯化的程序,提高诱导筛选效率。
在本研究中我们使用卡那霉素和庆大霉素对20株大肠杆菌进行诱导,得到2株血红素依赖型SCVs和3株未知营养依赖型的SCVs,并且本课题组前期诱导得到一株血红素依赖型沙门菌,表明此方法具有可行性。
但目前尚无细菌SCVs产生率的计算模型,因此未能对此方法的诱导效率进行定量比较。

根据依赖物质的不同可将细菌SCVs分为血红素依赖型、甲萘醌依赖型、胸腺嘧啶脱氧核苷依赖型和CO2依赖型,随着研究的深入更多类型的SCVs被相继报道,如甘氨酸依赖型SCVs、yijP(参与辅酶Q的合成)、relA(调控严谨反应)和lipA突变(硫辛酸合酶基因)形成的SCVs,以及多种未知依赖型SCVs。
但这些SCVs均具有生长缓慢、代谢降低、ATP合成不足和电子传递系统受阻等特性,并表现出全局性的变化。
在本研究中的血红素依赖型EC-SCVs和未知依赖型EC-SCVs均表现出生长缓慢、ATP含量降低、生理生化特性改变等。
另外,血红素依赖型EC-SCVs具有典型的SCVs菌落形态,在血平板上生长缓慢,呈无色透明的针尖状小菌落,并且生化特性发生改变等。

但3株未知依赖型EC-SCVs在血平板上的菌落更扁平、更透明,而在NA培养基上生长缓慢、呈透明状、圆形、扁平小菌落,与野生株相比差异明显。
在胸腺嘧啶脱氧核苷依赖型EC-SCV中的这种现象被报道过,其特殊的菌落形态可能与细胞壁的不完全分裂有关。
这种特殊的非典型SCVs菌落形态可能是EC-SCVs易被忽视的原因之一。
另外,本研究所有类型的EC-SCVs均不利用醋酸盐。
在大肠杆菌代谢过程中优先分解葡萄糖生成*酮丙**酸,随后在有氧生长条件下被氧化为醋酸盐,葡萄糖的分解利用与醋酸盐的积累成反比。
大肠杆菌也可由醋酸同化代谢系统(acs-yjcH-actP)从外界摄取醋酸盐。
当葡萄糖分解殆尽后,醋酸盐进入TCA循环被分解利用。
因此,三羧酸(TCA)循环的抑制会导致醋酸盐的利用障碍,而醋酸盐利用实验可作为SCVs鉴定的表型实验之一。

在电子转移过程中,需要甲萘醌(作为第一电子受体)和血红素(从甲萘醌接收电子,并且是细胞色素与过氧化氢酶的重要辅基)的参与,相关物质的合成障碍则会抑制电子传递链,进而导致ATP生成减少、细胞色素合成抑制以及抑制鞭毛蛋白MotB的作用(动力发生器的重要组成部分,可将质子穿过细胞质膜的运动与鞭毛马达的旋转结合起来,使细菌运动)。
在本研究中所有EC-SCVs的运动力均减弱,这也再次说明SCVs的能量代谢发生紊乱;但除血红素依赖型EC-SCVs外,其他EC-SCVs的溶血活性并未增强。
血细胞是细菌从外界获得血红素的重要途径之一,因此我们推测,血红素依赖型EC-SCVs为满足自身生存、繁殖与竞争的需求,通过激活某些调控因子增强溶血能力,但具体的调控机制仍需进一步研究。
与常见的细菌SCVs一样,本研究中的EC-SCVs的生物被膜形成能力增强,这一现象可能与sigB基因表达上调有关,并且较强的生物被膜形成能力有助于SCVs实现免疫逃避,从而降低宿主的清除作用。

Allison J等发现核心代谢基因突变(如中心碳和能量代谢有关基因)可导致细菌抗生素耐药性,这些基因突变导致基础呼吸降低,从而降低代谢毒性,最大限度地降低药物致死率,并且认为这是一种不同于以往认知(靶向修饰、药物失活和药物外排)的耐药机制。
本研究中的EC-SCVs也表现出与野生株不同的药物耐受性,尤其是对氨基糖苷类药物的耐受明显增强,其可能原因是氨基糖苷类药物进入细菌体内需要借助细胞膜内外的高膜电势能,而细胞膜电势能的改变可影响氨基糖苷类抗生素的摄入。
细菌SCVs因电子传递功能受阻导致膜内外电位差值较小,减少氨基糖苷类药物的吸收,进而对氨基糖苷类药物的敏感性降低。
与此不同的是,四环素除可依靠质子动力进入细菌细胞外,还可与Mg2+络合后经膜孔蛋白穿过细胞壁进入细菌细胞,并且此过程不需要消耗ATP,因此对代谢*制剂抑**不敏感,只要存在完整的细胞膜就可进入菌体。
本研究的结果也表明,EC-SCVs对四环素的耐受性并未增强,反而可能减弱(L16-1-S和L16-1-S-CN)。

不仅如此,头孢菌素类抗生素(干扰肽聚糖的合成)和多肽类抗生素(作用于脂多糖,增加细胞膜的通透性)均可作用于细菌的细胞壁,破坏细胞壁的功能,而细菌SCVs因能量合成受阻导致细胞壁发育不完全,进而可能增强这些作用于细胞壁的抗生素对SCVs的抑制或杀灭作用。
另外,血红素依赖型EC-SCVs对磺胺类药物的耐受性增强,磺胺类化合物是对氨基苯甲酸(4-aminobenzoic acid, PABA)的竞争性拮抗剂,而PABA是合成叶酸和细菌生长繁殖所必需的化合物。
磺胺类药物可逆地阻断叶酸的合成,从而具有抑菌作用。
可能正是因为EC-SCVs代谢障碍、生长缓慢,所需的PABA减少,从而对磺胺类药物的耐受性增强,但其机制还有待深入研究。
目前这种与能量代谢相关的药物耐受机制研究正成为热点,也成为细菌耐药问题解决的难点,同时也为抑菌药物的研发与应用提供新的思路。
本研究通过氨基糖苷类抗生素诱导大肠杆菌形成SCVs,并对其与野生株进行生物学特性比较分析,结果表明EC-SCV表现出生长抑制、代谢缓慢、ATP含量减少以及运动性降低、生物被膜增强和药物耐受性增强等特征,可为国内EC-SCVs的相关研究提供基础数据。
KAPER JB, NATARO JP, MOBLEY HLT. Pathogenic Escherichia coli[J]. Nature Reviews Microbiology, 2004, 2(2): 123-140.
HAMMERUM AM, HEUER OE. Human health hazards from antimicrobial-resistant Escherichia coli of animal origin[J]. Clinical Infectious Diseases, 2009, 48(7): 916-921.
PROCTOR RA, von EIFF C, KAHL BC, BECKER K, McNAMARA P, HERRMANN M, PETERS G. Small colony variants: a pathogenic form of bacteria that facilitates persistent and recurrent infections[J]. Nature Reviews Microbiology, 2006, 4(4): 295-305.